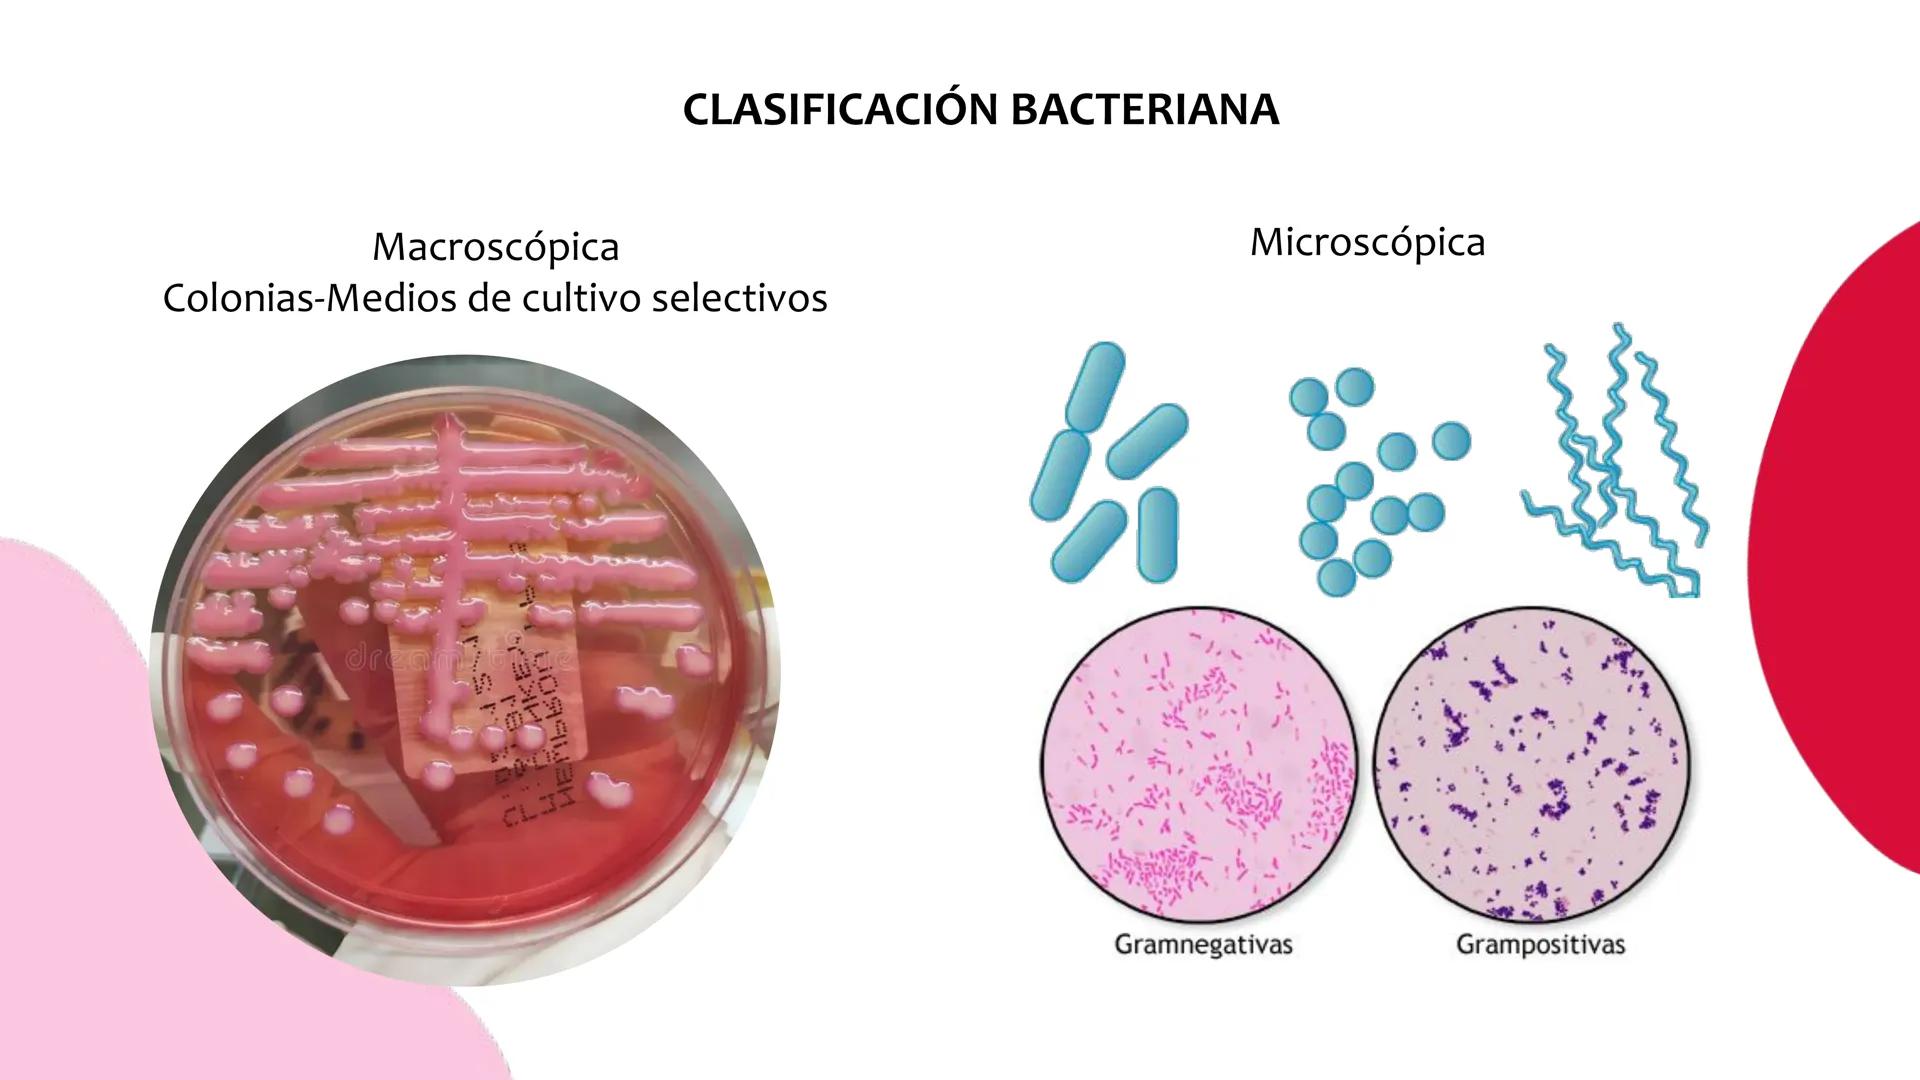
# Resistencia antimicrobiana y,
estructura y fisiología bacteriana Resistencia
antimicrobiana
Capacidad que tiene una bacteria
para sobrev

Las bacterias han desarrollado una increíble capacidad de supervivencia que... Mostrar más
Resistencia Antimicrobiana: Explicación y Aspectos Clave




















Resistencia Antimicrobiana y Estructura Bacteriana
¿Te imaginas una bacteria que puede sobrevivir a los antibióticos más potentes? Esa es exactamente la resistencia antimicrobiana: la capacidad que desarrollan las bacterias para resistir concentraciones de antibióticos que normalmente las matarían.
Este no es un fenómeno nuevo o artificial - es parte de la adaptabilidad natural de las bacterias. Han estado perfeccionando sus mecanismos de defensa durante millones de años, y ahora representan uno de los mayores desafíos médicos de nuestra época.
💡 Dato clave: La resistencia antimicrobiana es como una carrera armamentista entre humanos y bacterias - mientras desarrollamos nuevos antibióticos, ellas desarrollan nuevas formas de resistirlos.

Bacterias Multiresistentes: Las Más Peligrosas
La Organización Mundial de la Salud ha clasificado las bacterias más peligrosas en tres categorías de prioridad. Las de prioridad crítica incluyen Acinetobacter baumannii, la familia Enterobacteriaceae (como E. coli y Klebsiella), y Pseudomonas aeruginosa.
En prioridad alta encontramos patógenos como Staphylococcus aureus resistente a meticilina y Enterococcus faecium resistente a vancomicina. Estas bacterias causan infecciones hospitalarias graves y son extremadamente difíciles de tratar.
El grupo "ESKAPE" representa las seis bacterias más problemáticas: Enterococcus faecium, Staphylococcus aureus, Klebsiella pneumoniae, Acinetobacter baumannii, Pseudomonas aeruginosa y Enterobacter spp.
💡 Recuerda: El acrónimo ESKAPE literalmente significa "escapar" - estas bacterias "escapan" de la acción de los antibióticos.

Plásmidos: Los Mensajeros de la Resistencia
Los plásmidos son como pequeños discos duros bacterianos - moléculas circulares de ADN que pueden copiarse independientemente del cromosoma principal. Estos elementos genéticos móviles son cruciales para entender cómo se propaga la resistencia.
A través de la transferencia horizontal, las bacterias pueden intercambiar plásmidos entre especies diferentes. Es como si pudieran enviar mensajes de texto con las "instrucciones de supervivencia" a otras bacterias cercanas.
Los plásmidos frecuentemente contienen genes de resistencia que codifican para enzimas destructoras de antibióticos o sistemas de bombas de eflujo. Esta capacidad de compartir información genética hace que la resistencia se propague mucho más rápido.
💡 Piénsalo así: Los plásmidos son como archivos que se pueden copiar y pegar entre bacterias, compartiendo "trucos" de supervivencia.

Mecanismos de Resistencia Bacteriana
Las bacterias han desarrollado cuatro estrategias principales para resistir antibióticos. Primero, producen enzimas destructoras como las β-lactamasas que literalmente rompen los antibióticos en pedazos.
También pueden modificar las dianas donde actúan los antibióticos - es como cambiar la cerradura para que la llave ya no funcione. Las bombas de eflujo hiperactivas expulsan los antibióticos antes de que puedan hacer daño.
Finalmente, pueden reducir la permeabilidad de su membrana externa modificando el número de porinas, haciendo más difícil que los antibióticos entren a la célula.
💡 Analogía útil: Es como una fortaleza que puede destruir las balas enemigas, cambiar las cerraduras, expulsar intrusos y hacer las murallas más gruesas.

Estructura Bacteriana y Colonización
Para entender cómo las bacterias causan infección, necesitas conocer su arquitectura celular. La pared celular actúa como una armadura protectora, mientras que los flagelos les permiten nadar y desplazarse hacia sitios de infección.
Las fimbrias y pilis son estructuras clave para la colonización. Las fimbrias contienen adhesinas que permiten a las bacterias pegarse a las células del hospedero como velcro molecular.
El proceso de infección sigue cuatro etapas: entrada al organismo, colonización y adhesión, multiplicación e invasión, y finalmente el daño tisular. Cada etapa requiere estructuras bacterianas específicas.
💡 Visualízalo: Una bacteria es como un submarino microscópico equipado con ganchos (fimbrias), motores (flagelos) y armadura (pared celular).

Clasificación Bacteriana: Gram Positivas vs Negativas
La tinción de Gram divide las bacterias en dos grandes grupos basándose en su estructura de pared celular. Las Gram positivas tienen una pared gruesa con múltiples capas de peptidoglucano y ácidos teicoicos.
Las Gram negativas poseen una pared más delgada pero con una membrana externa adicional que contiene porinas. Esta diferencia estructural es crucial para entender qué antibióticos funcionan contra cada tipo.
La clasificación también se realiza por características macroscópicas (colonias en medios de cultivo) y microscópicas (forma y agrupación celular). Estos métodos son esenciales para el diagnóstico médico.
💡 Tip de laboratorio: Gram positivas = púrpuras, Gram negativas = rosadas. Esta diferencia de color refleja diferencias estructurales fundamentales.













Pensamos que nunca lo preguntarías...
¿Qué es Knowunity AI companion?
Nuestro compañero de IA está específicamente adaptado a las necesidades de los estudiantes. Basándonos en los millones de contenidos que tenemos en la plataforma, podemos dar a los estudiantes respuestas realmente significativas y relevantes. Pero no se trata solo de respuestas, el compañero también guía a los estudiantes a través de sus retos de aprendizaje diarios, con planes de aprendizaje personalizados, cuestionarios o contenidos en el chat y una personalización del 100% basada en las habilidades y el desarrollo de los estudiantes.
¿Dónde puedo descargar la app Knowunity?
Puedes descargar la app en Google Play Store y Apple App Store.
¿Knowunity es totalmente gratuito?
¡Sí lo es! Tienes acceso totalmente gratuito a todo el contenido de la app, puedes chatear con otros alumnos y recibir ayuda inmeditamente. Puedes ganar dinero utilizando la aplicación, que te permitirá acceder a determinadas funciones.
Contenidos más populares de Biología
9Sistema óseo
Función, tipos, etcétera
Mapa metabólico
Mapa metabólico, glucólisis, gluconeogénesis, lípidos, vía de las pentosas, ciclo de krebs
Célula animal y vegetal
En resumen, este documento te habla sobre qué es, características, diferencias y similitudes de la célula animal y célula vegetal.💗
Mapa mental - Sistema Nervioso
Mapa mental sobre el sistema nervioso
Guía de estudio EXANI-II
Guia de estudio a cerca del examen universitario EXANI-II, apoyo para un examen de ingreso próximo 2026.
Tejido oseo
Tejido oseo células
Biología celular
tipos de células ,partes de una celula ,funciones y ejemplos
La celula
Apuntes para estudiar
Glucólisis: Ruta Metabólica Esencial
Evalúa tu comprensión de la glucólisis, sus mecanismos, enzimas clave y su importancia biológica en el cuerpo humano.
Contenidos más populares
9Jerarquía de operaciones
Te enseña la jerarquía de operaciones y también te ecplica que son y como las puedes hacer
química
química
Sistema óseo
Función, tipos, etcétera
Mapa metabólico
Mapa metabólico, glucólisis, gluconeogénesis, lípidos, vía de las pentosas, ciclo de krebs
Célula animal y vegetal
En resumen, este documento te habla sobre qué es, características, diferencias y similitudes de la célula animal y célula vegetal.💗
Matemáticas
matemáticas
Examen mate
matemáticas
Mapa mental - Sistema Nervioso
Mapa mental sobre el sistema nervioso
Historia ECOEMS (Comipems)
Breve resumen de los temas de historia universal del examen del examen de media superior ECOEMS del valle de México
¿No encuentras lo que buscas? Explora otros temas.
Reseñas de nuestros usuarios. Ellos obtuvieron todo lo bueno — y tú también lo harías.
La app es muy fácil de usar y está muy bien diseñada. Hasta ahora he encontrado todo lo que estaba buscando y he podido aprender mucho de las presentaciones. Definitivamente utilizaré la aplicación para un examen de clase. Y, por supuesto, también me sirve mucho de inspiración.
Esta app es realmente genial. Hay tantos apuntes de clase y ayuda [...]. Tengo problemas con matemáticas, por ejemplo, y la aplicación tiene muchas opciones de ayuda. Gracias a Knowunity, he mejorado en mates. Se la recomiendo a todo el mundo.
Vaya, estoy realmente sorprendida. Acabo de probar la app porque la he visto anunciada muchas veces y me he quedado absolutamente alucinada. Esta app es LA AYUDA que quieres para el insti y, sobre todo, ofrece muchísimas cosas, como ejercicios y hojas informativas, que a mí personalmente me han sido MUY útiles.
Resistencia Antimicrobiana: Explicación y Aspectos Clave
Las bacterias han desarrollado una increíble capacidad de supervivencia que está complicando el tratamiento de infecciones: la resistencia antimicrobiana. Este fenómeno natural de adaptación está creando "superbacterias" que pueden resistir múltiples antibióticos, convirtiendo infecciones simples en amenazas serias para la... Mostrar más

Inscríbete para ver los apuntes. ¡Es gratis!
- Acceso a todos los documentos
- Mejora tus notas
- Únete a millones de estudiantes
Resistencia Antimicrobiana y Estructura Bacteriana
¿Te imaginas una bacteria que puede sobrevivir a los antibióticos más potentes? Esa es exactamente la resistencia antimicrobiana: la capacidad que desarrollan las bacterias para resistir concentraciones de antibióticos que normalmente las matarían.
Este no es un fenómeno nuevo o artificial - es parte de la adaptabilidad natural de las bacterias. Han estado perfeccionando sus mecanismos de defensa durante millones de años, y ahora representan uno de los mayores desafíos médicos de nuestra época.
💡 Dato clave: La resistencia antimicrobiana es como una carrera armamentista entre humanos y bacterias - mientras desarrollamos nuevos antibióticos, ellas desarrollan nuevas formas de resistirlos.

Inscríbete para ver los apuntes. ¡Es gratis!
- Acceso a todos los documentos
- Mejora tus notas
- Únete a millones de estudiantes
Bacterias Multiresistentes: Las Más Peligrosas
La Organización Mundial de la Salud ha clasificado las bacterias más peligrosas en tres categorías de prioridad. Las de prioridad crítica incluyen Acinetobacter baumannii, la familia Enterobacteriaceae (como E. coli y Klebsiella), y Pseudomonas aeruginosa.
En prioridad alta encontramos patógenos como Staphylococcus aureus resistente a meticilina y Enterococcus faecium resistente a vancomicina. Estas bacterias causan infecciones hospitalarias graves y son extremadamente difíciles de tratar.
El grupo "ESKAPE" representa las seis bacterias más problemáticas: Enterococcus faecium, Staphylococcus aureus, Klebsiella pneumoniae, Acinetobacter baumannii, Pseudomonas aeruginosa y Enterobacter spp.
💡 Recuerda: El acrónimo ESKAPE literalmente significa "escapar" - estas bacterias "escapan" de la acción de los antibióticos.

Inscríbete para ver los apuntes. ¡Es gratis!
- Acceso a todos los documentos
- Mejora tus notas
- Únete a millones de estudiantes
Plásmidos: Los Mensajeros de la Resistencia
Los plásmidos son como pequeños discos duros bacterianos - moléculas circulares de ADN que pueden copiarse independientemente del cromosoma principal. Estos elementos genéticos móviles son cruciales para entender cómo se propaga la resistencia.
A través de la transferencia horizontal, las bacterias pueden intercambiar plásmidos entre especies diferentes. Es como si pudieran enviar mensajes de texto con las "instrucciones de supervivencia" a otras bacterias cercanas.
Los plásmidos frecuentemente contienen genes de resistencia que codifican para enzimas destructoras de antibióticos o sistemas de bombas de eflujo. Esta capacidad de compartir información genética hace que la resistencia se propague mucho más rápido.
💡 Piénsalo así: Los plásmidos son como archivos que se pueden copiar y pegar entre bacterias, compartiendo "trucos" de supervivencia.

Inscríbete para ver los apuntes. ¡Es gratis!
- Acceso a todos los documentos
- Mejora tus notas
- Únete a millones de estudiantes
Mecanismos de Resistencia Bacteriana
Las bacterias han desarrollado cuatro estrategias principales para resistir antibióticos. Primero, producen enzimas destructoras como las β-lactamasas que literalmente rompen los antibióticos en pedazos.
También pueden modificar las dianas donde actúan los antibióticos - es como cambiar la cerradura para que la llave ya no funcione. Las bombas de eflujo hiperactivas expulsan los antibióticos antes de que puedan hacer daño.
Finalmente, pueden reducir la permeabilidad de su membrana externa modificando el número de porinas, haciendo más difícil que los antibióticos entren a la célula.
💡 Analogía útil: Es como una fortaleza que puede destruir las balas enemigas, cambiar las cerraduras, expulsar intrusos y hacer las murallas más gruesas.

Inscríbete para ver los apuntes. ¡Es gratis!
- Acceso a todos los documentos
- Mejora tus notas
- Únete a millones de estudiantes
Estructura Bacteriana y Colonización
Para entender cómo las bacterias causan infección, necesitas conocer su arquitectura celular. La pared celular actúa como una armadura protectora, mientras que los flagelos les permiten nadar y desplazarse hacia sitios de infección.
Las fimbrias y pilis son estructuras clave para la colonización. Las fimbrias contienen adhesinas que permiten a las bacterias pegarse a las células del hospedero como velcro molecular.
El proceso de infección sigue cuatro etapas: entrada al organismo, colonización y adhesión, multiplicación e invasión, y finalmente el daño tisular. Cada etapa requiere estructuras bacterianas específicas.
💡 Visualízalo: Una bacteria es como un submarino microscópico equipado con ganchos (fimbrias), motores (flagelos) y armadura (pared celular).

Inscríbete para ver los apuntes. ¡Es gratis!
- Acceso a todos los documentos
- Mejora tus notas
- Únete a millones de estudiantes
Clasificación Bacteriana: Gram Positivas vs Negativas
La tinción de Gram divide las bacterias en dos grandes grupos basándose en su estructura de pared celular. Las Gram positivas tienen una pared gruesa con múltiples capas de peptidoglucano y ácidos teicoicos.
Las Gram negativas poseen una pared más delgada pero con una membrana externa adicional que contiene porinas. Esta diferencia estructural es crucial para entender qué antibióticos funcionan contra cada tipo.
La clasificación también se realiza por características macroscópicas (colonias en medios de cultivo) y microscópicas (forma y agrupación celular). Estos métodos son esenciales para el diagnóstico médico.
💡 Tip de laboratorio: Gram positivas = púrpuras, Gram negativas = rosadas. Esta diferencia de color refleja diferencias estructurales fundamentales.

Inscríbete para ver los apuntes. ¡Es gratis!
- Acceso a todos los documentos
- Mejora tus notas
- Únete a millones de estudiantes

Inscríbete para ver los apuntes. ¡Es gratis!
- Acceso a todos los documentos
- Mejora tus notas
- Únete a millones de estudiantes

Inscríbete para ver los apuntes. ¡Es gratis!
- Acceso a todos los documentos
- Mejora tus notas
- Únete a millones de estudiantes
Inscríbete para ver los apuntes. ¡Es gratis!
- Acceso a todos los documentos
- Mejora tus notas
- Únete a millones de estudiantes

Inscríbete para ver los apuntes. ¡Es gratis!
- Acceso a todos los documentos
- Mejora tus notas
- Únete a millones de estudiantes

Inscríbete para ver los apuntes. ¡Es gratis!
- Acceso a todos los documentos
- Mejora tus notas
- Únete a millones de estudiantes

Inscríbete para ver los apuntes. ¡Es gratis!
- Acceso a todos los documentos
- Mejora tus notas
- Únete a millones de estudiantes

Inscríbete para ver los apuntes. ¡Es gratis!
- Acceso a todos los documentos
- Mejora tus notas
- Únete a millones de estudiantes

Inscríbete para ver los apuntes. ¡Es gratis!
- Acceso a todos los documentos
- Mejora tus notas
- Únete a millones de estudiantes

Inscríbete para ver los apuntes. ¡Es gratis!
- Acceso a todos los documentos
- Mejora tus notas
- Únete a millones de estudiantes

Inscríbete para ver los apuntes. ¡Es gratis!
- Acceso a todos los documentos
- Mejora tus notas
- Únete a millones de estudiantes

Inscríbete para ver los apuntes. ¡Es gratis!
- Acceso a todos los documentos
- Mejora tus notas
- Únete a millones de estudiantes

Inscríbete para ver los apuntes. ¡Es gratis!
- Acceso a todos los documentos
- Mejora tus notas
- Únete a millones de estudiantes
Pensamos que nunca lo preguntarías...
¿Qué es Knowunity AI companion?
Nuestro compañero de IA está específicamente adaptado a las necesidades de los estudiantes. Basándonos en los millones de contenidos que tenemos en la plataforma, podemos dar a los estudiantes respuestas realmente significativas y relevantes. Pero no se trata solo de respuestas, el compañero también guía a los estudiantes a través de sus retos de aprendizaje diarios, con planes de aprendizaje personalizados, cuestionarios o contenidos en el chat y una personalización del 100% basada en las habilidades y el desarrollo de los estudiantes.
¿Dónde puedo descargar la app Knowunity?
Puedes descargar la app en Google Play Store y Apple App Store.
¿Knowunity es totalmente gratuito?
¡Sí lo es! Tienes acceso totalmente gratuito a todo el contenido de la app, puedes chatear con otros alumnos y recibir ayuda inmeditamente. Puedes ganar dinero utilizando la aplicación, que te permitirá acceder a determinadas funciones.
Contenidos más populares de Biología
9Sistema óseo
Función, tipos, etcétera
Mapa metabólico
Mapa metabólico, glucólisis, gluconeogénesis, lípidos, vía de las pentosas, ciclo de krebs
Célula animal y vegetal
En resumen, este documento te habla sobre qué es, características, diferencias y similitudes de la célula animal y célula vegetal.💗
Mapa mental - Sistema Nervioso
Mapa mental sobre el sistema nervioso
Guía de estudio EXANI-II
Guia de estudio a cerca del examen universitario EXANI-II, apoyo para un examen de ingreso próximo 2026.
Tejido oseo
Tejido oseo células
Biología celular
tipos de células ,partes de una celula ,funciones y ejemplos
La celula
Apuntes para estudiar
Glucólisis: Ruta Metabólica Esencial
Evalúa tu comprensión de la glucólisis, sus mecanismos, enzimas clave y su importancia biológica en el cuerpo humano.
Contenidos más populares
9Jerarquía de operaciones
Te enseña la jerarquía de operaciones y también te ecplica que son y como las puedes hacer
química
química
Sistema óseo
Función, tipos, etcétera
Mapa metabólico
Mapa metabólico, glucólisis, gluconeogénesis, lípidos, vía de las pentosas, ciclo de krebs
Célula animal y vegetal
En resumen, este documento te habla sobre qué es, características, diferencias y similitudes de la célula animal y célula vegetal.💗
Matemáticas
matemáticas
Examen mate
matemáticas
Mapa mental - Sistema Nervioso
Mapa mental sobre el sistema nervioso
Historia ECOEMS (Comipems)
Breve resumen de los temas de historia universal del examen del examen de media superior ECOEMS del valle de México
¿No encuentras lo que buscas? Explora otros temas.
Reseñas de nuestros usuarios. Ellos obtuvieron todo lo bueno — y tú también lo harías.
La app es muy fácil de usar y está muy bien diseñada. Hasta ahora he encontrado todo lo que estaba buscando y he podido aprender mucho de las presentaciones. Definitivamente utilizaré la aplicación para un examen de clase. Y, por supuesto, también me sirve mucho de inspiración.
Esta app es realmente genial. Hay tantos apuntes de clase y ayuda [...]. Tengo problemas con matemáticas, por ejemplo, y la aplicación tiene muchas opciones de ayuda. Gracias a Knowunity, he mejorado en mates. Se la recomiendo a todo el mundo.
Vaya, estoy realmente sorprendida. Acabo de probar la app porque la he visto anunciada muchas veces y me he quedado absolutamente alucinada. Esta app es LA AYUDA que quieres para el insti y, sobre todo, ofrece muchísimas cosas, como ejercicios y hojas informativas, que a mí personalmente me han sido MUY útiles.